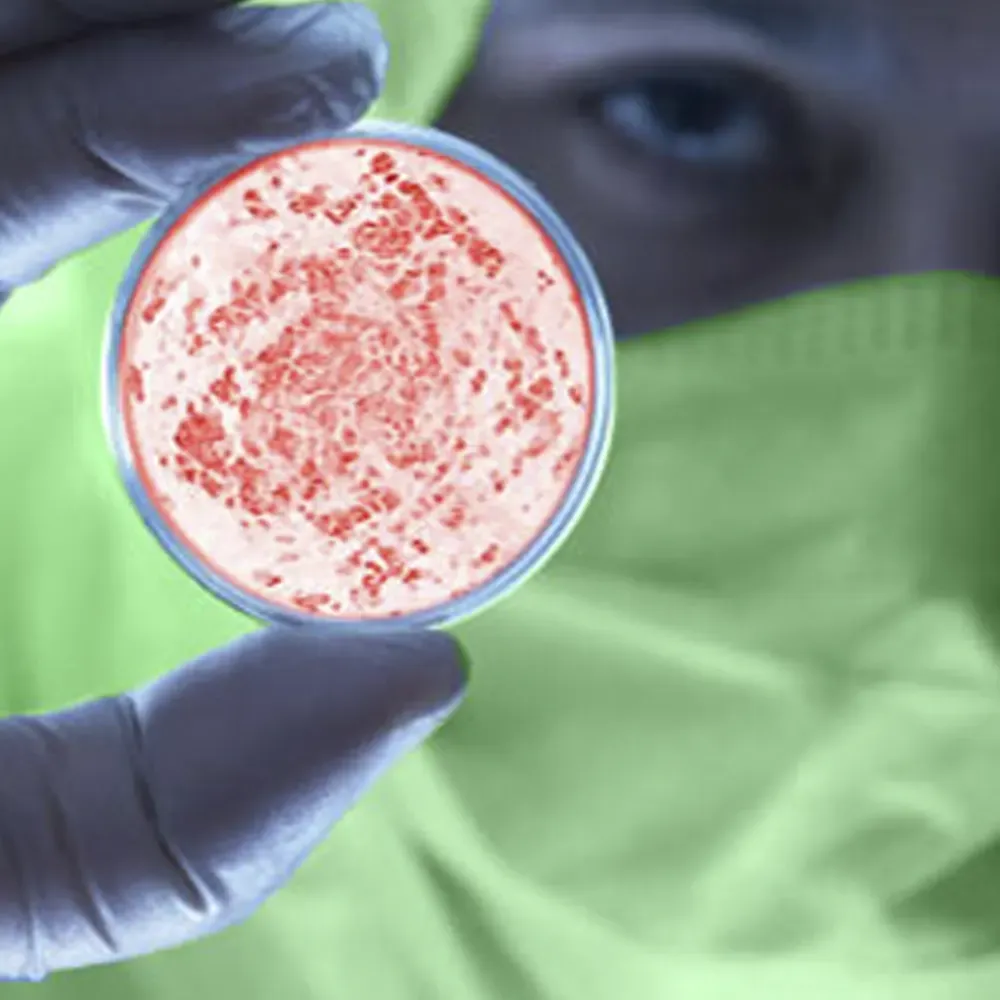

Eliminación de Virus
¿Tu ordenador está infectado con virus, malware o ransomware?
En Consiste Informática ofrecemos servicios de eliminación de virus a empresas y particulares. Podemos ayudarte con la instalación de un buen servicio antivirus para prevenir las infecciones y eliminar los virus que ya te hayan infectado.
¡Mantén tus dispositivos seguros!
Más vale prevenir que curar
¿Cuánto valen tus datos? ¿podrías reponerlos si los perdieses?
Las últimas familias de virus encriptan toda tu información impidiendo que puedas acceder a ella. Por eso, más que nuca, es fundamental contar con un buen sistema de copia de seguridad y un buen software antivirus instalado que nos ayude a prevenir la entrada de nuevo software malicioso.
En la actualidad, los virus informáticos son una de las mayores amenazas para la seguridad en línea y no solo dañan tus dispositivos y encriptan tus archivos, sino que además comprometen tu información laboral, personal y financiera. Por esta razón, aunque los antivirus gratuitos son mejores que nada, es fundamental contar con un buen software antivirus que te proporcione la protección que necesitas.
Instala siempre Software Original
La mayoría de los activadores y cracks contienen virus
Cuando instalas cualquier tipo de software pirata en tu ordenador estás haciendo un ejercicio de confianza ciega en la persona que ha creado el crack, sin tener en cuenta que ese Robin Hood podría (y la mayoría de las veces lo hacen) haber metido un código en su software que robe tus contraseñas y datos importantes.
En Consiste Informática, nuestros expertos en seguridad informática utilizan las últimas herramientas y técnicas para detectar y eliminar virus, malware y ransomware de tus dispositivos. Desde los virus más comunes hasta los más sofisticados, te ofrecemos una solución rápida y efectiva para mantener tus dispositivos seguros.
Además, nos aseguramos de que nuestros servicios de eliminación de virus sean accesibles para todo tipo de usuarios, por lo que ofrecemos precios competitivos y soluciones personalizadas para tus necesidades específicas.
¿Quieres mantener tus dispositivos seguros y protegidos contra las amenazas en línea? Confía en el servicio de eliminación de virus de Consiste Informática. Contáctanos hoy mismo y te ayudaremos a proteger tus dispositivos de los virus informáticos.

- ¿Infectado por un Virus?
- Tenemos servicio de Urgencias
